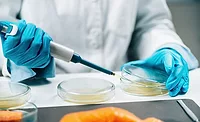
microbiological analysis or culturing

The Future of Food Safety Microbiology Markets
The markets surrounding microbiology testing have been changing rapidly in recent years—a change that will continue over the long term

Image credit: luchschen/iStock / Getty Images Plus via Getty Images
"Predictions are difficult, especially about the future." —Yogi Berra
These words of wisdom are attributed to Yogi Berra, the former Yankees catcher, manager, and coach, and count as only one of the many pearls of wisdom imparted to us by Yogi. This one, however, applies to what we may see in the development of food safety microbiology markets in the coming years.
What do I mean by that? The markets surrounding microbiology testing have been changing rapidly in recent years, and this change will continue (and possibly accelerate) over the long term. The rapidly increasing sensitivity of diagnostic testing technology is not only enabling us to see things that previously went undetected, but also opening up new regulatory challenges.
An impediment to this evaluation is our cloudy short-term view. Current conditions in worldwide markets at the time of this writing are unstable. The recovery from COVID-19, the resulting supply chain disruptions, global inflation, currency fluctuations, and the war in Ukraine—which has disrupted food markets in eastern Europe as other countries attempt to make up for lost food production from Ukraine and Russia—are but a few of the factors making the short-term view difficult to see.
Let us see if Yogi was right, as we take a look at some of the key factors that will affect testing markets in the coming years.
Inflation
The economic factors resulting from the recovery from COVID-19 and supply chain issues have driven inflation rates not seen in decades. At the time of this writing, we are seeing inflation rates in the U.S. and Canada in the range of 7–8 percent and at 10 percent in the EU. Many other areas of the world are dealing with inflation rates close to 15–20 percent. This further adds to the costs of new tests, reducing adoption.
The differences in the rates of inflation and other factors also cause an increase in the relative strength of the dollar and the euro. These stronger currencies in the home countries of most of the developers of advanced diagnostic tests adds to the relative prices of their tests and drives users back to lower-priced tests. This is especially the case in areas where the use of rapid tests is not as saturated as it is in North America and Western Europe. We frequently hear from food processors in other regions that a major impediment to adoption of advanced methods is that they are "too expensive." With lower labor costs for media preparation and the higher acceptability of being able to use traditional growth media methods, many of these companies will either revert or fail to convert in the first place, as high prices present a disincentive.
Looking for quick answers on food safety topics?
Try Ask FSM, our new smart AI search tool.
Ask FSM →
Inflation will also reduce the overall volume of testing in many markets. To put this point bluntly, many companies will simply test less than they have been in order to reduce costs. This will not be the case for the multinational processors that have largely harmonized their testing across geographies, but it will be the case for many smaller and mid-sized processors around the world that do not have the discipline to continue testing (and other food safety functions) in the face of higher costs.
For many of us, the thought of reducing food safety testing to save a little money seems risky, if not downright dangerous, but this thought is not universal. Unlike the food markets in North America and Western Europe, where significant consolidation of producers has occurred and a substantial share of the market is dominated by large, multinational companies, food production in other world regions is largely completed by very small producers with perhaps fewer than 50 employees. These companies will be more likely to reduce their food safety efforts in order to reduce costs.
One expert I work with characterized one of these national markets by saying, "The largest 5 percent of the plant locations in the market will be multinationals with very high standards, and the next 5–10 percent will be export-oriented, larger, domestic companies that will do the minimum to meet the necessary standards." He characterized the remaining 75–80 percent as "better not to know." The companies in this last category will likely reduce their volume of testing, and they will use the least expensive methods possible. This will reduce the overall value of the market, at least in the short term, creating an impediment to growth until market and price stability return.
Pricing
When projecting the size and growth of testing markets, the two most important factors are the volume of testing and the pricing of those tests, which together result in the overall market value. In the more than 25 years that Strategic Consulting has been analyzing food safety testing markets, the average growth of overall microbiology test volume has been approximately 6 percent. In that same period, the overall growth of test value, driven by pricing, has exceeded test volume growth by an average of roughly 1–2 percentage points, leading to a market compound annual growth rate (CAGR) of 7–8 percent.
Much of this increase can be attributed to the conversion from less expensive, traditional technologies to more expensive, but more accurate rapid methods. For example, when PCR testing for pathogen detection was introduced, the switch to PCR (valued at approximately $10/test at the time of conversion) from the use of low-cost plated media tests (valued at approximately $1/test) greatly increased the average cost per test for pathogen analysis. The additional benefits delivered by conversion to rapid methods also made test users less price-conscious, providing test vendors the ability to raise prices on a regular basis. These factors led to a high rate of market value growth.
In recent years, however, this dynamic has changed significantly. The rate of test volume growth continues at near-to-historic rates, but the rate of conversion to higher-priced technologies has slowed, and the pricing power of test developers has diminished.
In many markets, especially those in North America and Europe, saturation in the use of rapid test methods has eliminated value increases from conversion. This changes the source of growth for the vendors of testing technologies from new adopters to competitive conversions (from one competing rapid technology to another). This increases market competition, leading to more intense price competition.
This is exactly what we have seen in recent years. For example, average market pricing for PCR tests has dropped from $8–10/test in 2018 to closer to $5–6/test now. This trend also goes for instrument-based immunoassay, with test pricing moving from $6–7/test in 2018 to an average of $4–5/test currently. In some world markets, where price sensitivity has always been a greater driver and higher-priced rapid methods have seen far lower conversion rates, this bump in value from method conversions has not been seen, and pricing for traditional test methods has been more stable. This may change, however, as the pricing of rapid methods continues to decrease, making these tests more competitive in developing markets. As the rapid test vendors move into these markets looking for growth, they will need to compete on price with the existing, lower-priced, traditional growth methods. This scenario will encourage conversion in these markets, which will increase regional market value growth, but at lower price levels than in other markets and at correspondingly lower growth rates. This price competition may also contribute to the erosion of test pricing and, in fact, we have seen some evidence of pricing for PCR and automated immunoassay as low as $3–4/test in these regions.
Outsourcing
While challenges will always exist, developers of diagnostic tests will be the beneficiaries of the steady growth in this market. The real beneficiaries, however, may be commercial laboratories. Testing volumes continue to grow at mid-single-digit rates, but more of this volume is being moved from in-plant labs to commercial laboratories. This is the case with all food testing (e.g., nutritional analysis, contaminants, and microbiology) and especially for analysis of food pathogens. While the market volume for pathogen analysis is growing at approx. 6–7 percent per year, pathogen test volumes in commercial labs have been growing closer to 12–14 percent per year due to outsourcing. An estimated 60 percent of pathogen tests in North America, 50 percent of tests in Europe, and 30 percent in other regions are outsourced to a commercial laboratory.
This growth in outsourcing will continue until it reaches a level of market saturation in each market. A reversal of this trend is unlikely, as little appetite exists to bring analysis back into the plant—especially for pathogens. When we forecast this demand for commercial laboratory services, we project that commercial lab market value growth will continue to exceed 10–12 percent per year over the next 2–3 years. This will drive development in the market with growth in the number of lab locations, especially for the major players, but also in mergers and acquisitions, which will lead to further consolidation that will create larger and larger lab networks.
This development, however, may come as difficult news for the producers of diagnostic tests. As outsourcing grows, all but the largest plant labs will discontinue or reduce their in-house testing, and commercial labs will merge and consolidate into fewer and larger lab networks. This means that the customer base for diagnostic test developers will be bifurcated to very large processor plant labs and very large commercial lab companies. The scale of each of these customer types will increase their bargaining power, and this will again put pressure on the prices of diagnostic tests. While test volume may continue to grow, this price pressure will cause market values to flatten or, in some cases, to shrink as prices decrease at a faster rate than volume growth.
Test developers will need to turn to innovation and offer better and faster tests to maintain growth and reduce their costs to protect their margins. Since many of the technologies used in this market (other than traditional growth media) have been in the market for 25 years or less, the developing competitive pressure may be higher than any of the competitors in this market have ever experienced. As with many maturing markets, the companies that prove best at innovation and business discipline will benefit and gain share, while others will fall behind and see their businesses suffer.
Growth Media
The use of traditional growth media for microbiology has been around since before the time of Louis Pasteur. With the introduction of rapid and especially instrument-based test methods, however, the slow death of the use of growth media has been widely forecast. Much to the dismay of the forecasters, this phasing out of growth media testing has not occurred. In the surveys we conduct with food processors around the world, at least 65–70 percent of all microbiology tests conducted use traditional, non-instrument-based, growth media tests. This should not be surprising as these methods are accurate, easy to run, and inexpensive. Also, as many microbiologists that I work with like to say, "The microorganisms get a vote in what happens." This means that the bugs do not always cooperate, and many times a medium optimized for the growth of a specific microorganism is still the best way to get it to grow so that it can be found.
The growth media sold in the food safety market generally falls into one of two categories:
- Dry powdered media (dehydrated culture media) that the user prepares in their own lab (or "media kitchens")
- Pre-prepared or "convenience" format media, sold ready-to-use with no further preparation needed by the user (e.g., film plates, prepared plated media in dishes, dip slides, contact plates, swabs, and similar formats).
While the products in this "convenience" format are nonetheless growth media tests, because of their portability, savings in labor and laboratory infrastructure, and other advantages, we see conversion to these formats from dry media, with volume growth in this category running a few points ahead of the overall market.
This conversion will not be uniform around the world.Processors in the U.S. and Canada tend to use these labor-saving methods due to their lean, low-headcount operations. Processors in Western Europe, on the other hand, find it more difficult to reduce headcount, and so maintaining employees to staff a media preparation kitchen is possible. Elsewhere in the world, where the cost of this convenience is generally considered too high and the cost of labor is not, processors tend to see convenience methods as "expensive" and find cost advantages in preparing their own media. However, development and the resulting higher labor costs will eventually change this calculation. This will drive additional conversion to higher-priced methods in new markets and result in above-average growth rates in the mid- to long-term outlook.
Growth in Developing Countries
A trend in these markets that will undoubtedly continue is steady, long-term growth. The source of this growth will not come from the same geographies as in the past 25 years, but rather from the growth of markets in the developing world. The potential of these markets is substantial. In testing alone, the current underserved market far outstrips the current existing market.
For example, in one of the reports that Strategic Consulting issues on global microbiology markets, we make the point that if the intensity (measured as tests/person in the region) of food safety testing typically seen in North America and Europe were to be common in the rest of the world, then the additional test volume would be at least three times the size of the existing market. This means that we have a long way to go before we reach a saturated, fully mature world market.
This also means that long-term market opportunities and growth will shift to Asia, Latin America, and Africa. These world regions will also see higher population growth than the developed world, adding to the demand for more food production, especially from local sources, and bringing more processing locations to the market in addition to higher test volumes from each facility.
Harking back to the beginning of this article, Yogi Berra is also credited with saying, "The future ain't what is used to be." This is certainly the case for microbiology in food safety. Since this is a relatively young business discipline and market area, it has not yet undergone the changes that most markets experience. These challenges are coming, but they also bring the promise of steady, long-term growth with abundant opportunities for those companies that can adapt.
Bob Ferguson is President of Strategic Consulting Inc. and can be reached at bobferguson9806@gmail.com or on Twitter at @SCI_Ferguson.